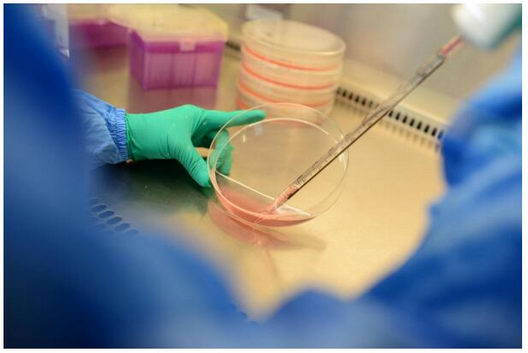
ͻҽҩ򿨲ƿ ҩΪǻҺṩȫƷ

肿瘤治疗一直是中国在世界生物医学领域被卡脖子的重点领域,而在此其中,恶性肿瘤也是导致患者出现胸腔积液的重要因素!但就在前不久,中国肿瘤治疗领域里出现一种治疗胸腔积液的创新技术——“载药囊泡治疗肿瘤技术”,目前在胸腔积液和实体瘤治疗方面均表现出良好的效果,而此项技术便是由湖北盛齐安生物科技股份有限公司自主研发,属于中国原创肿瘤治疗技术。

据悉,囊泡是肿瘤细胞在活化或凋亡过程中细胞骨架发生改变,由细胞膜包裹细胞内容物以“出芽”的方式释放到细胞外的囊泡状结构。它是一种天然物质,此前被视为细胞释放的废弃物,从2009年开始,“载药囊泡治疗肿瘤技术”发明人黄波就率先将其用于肿瘤治疗。
作为一种天然载体,囊泡可包裹化疗药物、溶瘤病毒等,还可作为一种理想的肿瘤疫苗。同时以肿瘤细胞释放的囊泡与化疗药物有机结合,更可以靶向杀伤肿瘤干细胞,解决了肿瘤治疗的耐药和易复发等难题。而在载药囊泡治疗肿瘤技术的诸多优势中,它针对肿瘤干细胞的靶向杀伤作用更突出。据介绍,肿瘤细胞有不同的亚群,根据生物机械力学原理,干性细胞虽是最危险的亚群,但它非常柔软,更容易吞噬载药囊泡,通俗理解,即可通过变形将载药囊泡“吃”进去。
众所周知,肿瘤组织中存在自我更新和无限增殖潜能的肿瘤干细胞,具有强耐药性。然而这也难不倒“载药囊泡治疗肿瘤技术”,通过此项技术,其载药囊泡被肿瘤干细胞吞噬后进入溶酶体,在动力蛋白的牵引下溶酶体沿着微管运动到细胞核附近,释放化疗药物,化疗药物沿着核孔进入细胞核,彻底杀伤肿瘤干细胞,避免耐药。
而在后续的持续研究中,载药囊泡治疗肿瘤技术的诸多优点被一一发现,据介绍,用载药囊泡治疗恶性胸腔积液和腹水,从前期临床试验来看,在一个星期之内,患者胸水中99%的肿瘤细胞被清除掉!同时,随着不断的持续研究,载药囊泡治疗肿瘤技术的诸多优点被一一发现,在胆管癌、肺癌等实体瘤治疗中也取得良好的临床效果!

据了解,载药囊泡治疗肿瘤技术是由湖北盛齐安生物科技股份有限公司自主研发并具有独立知识产权,已取得了中国、中国香港、美国和欧盟专利授权,相关研究论文已发表在Nature Materials、Nature Communications、Cell Research等国际知名学术期刊上,并取得多项政策支持,包括国家重点新产品计划项目、湖北省技术创新专项重大项目等20多项重大科研项目。在科技部组织实施的国家重点基础研究发展计划(亦称“973计划”)中,获3名院士推荐并肯定载药囊泡治疗肿瘤技术的原创性成果、重大创新和突破性进展。
更多内容请关注盛齐安官方网站http://www.soundnybio.com/index.html或微信公众号了解详情!
小贴士:湖北盛齐安生物科技股份有限公司成立于2009年,是一家专注于“载药囊泡治疗肿瘤技术”研发、应用与推广的高科技生物医药企业,于2017年2月正式挂牌新三板。2017年9月至今,盛齐安“载药囊泡治疗肿瘤技术”先后取得天津市、湖北省、深圳市和安徽省的新增医疗服务项目价格批示,将在恶性胸腔积液(也称“胸水”)、恶性腹水及胆管癌、肺癌等实体瘤方面开展临床应用。




















